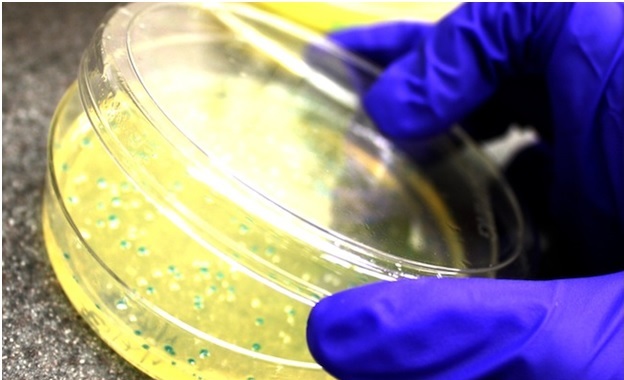

Subcloning Services / Cloning Services
Antibody Construction
Antibodies targeted toward specific diseases or targets can be codon optimized for maximum expression in the host organism. Also, an antibody library can be constructed to screen for the most efficient antibody variant.
Organism Production Optimization
Optimize expression of genes related to resource production to maximize industrial biological production efficiency.
Gene Construction
Get difficult-to-obtain DNA sequences without a template and upgrade the quality of your research by constructing hypothetical genes.
Protein Modification
Codon optimization can increase protein expression efficiency, and a mutant library derived from this process can yield proteins with increased function. Optimizations include secondary structure removal, and repeat reduction as well as organism optimizations.
To find out more details about this custom service, Please request a quote today.